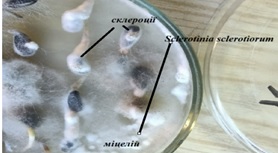

Аналіз мікобіоти насіння: нові види та їх значення для агрономії
Аналіз мікобіоти насіння: нові види та їх значення для агрономії
Мікобіота насіння є важливим компонентом екосистеми рослин, оскільки впливає на їх здоров’я, розвиток та стійкість до захворювань. Аналіз мікобіоти насіння дозволяє виявити наявність грибкових патогенів, які можуть впливати на врожайність та якість агрокультур. В Україні активно проводяться дослідження, спрямовані на визначення спектру грибів, що заселяють насіння основних сільськогосподарських культур.
Зокрема, ми здійснили визначення нових видів грибів у мікобіоті пшениці, що є важливим для сільського господарства України. До нових видів, які були виявлені в дослідженнях, належать: Alternaria arborescens E.G. Simmons, Alternaria botrytis (Preuss) Woudenb. & Crous, Alternaria gaisen Nagano ex Hara, Arthrinium arundinis (Corda) Dyko & B. Sutton, Harzia acremonioides Les Mucédinées, Chaetomium rectangulare Asgari & Zare, Nigrospora osmanthi Mei Wang & L. Cai, Nigrospora sphaerica (Sacc.) E.W. Mason.
Ці види грибів мають значення як потенційні патогени, здатні викликати різноманітні захворювання, такі як альтернаріоз, фузаріоз або артідіоз. Деякі з них можуть бути потенційними джерелами токсинів, що погіршують якість насіння і знижують врожайність. Наприклад, деякі види Alternaria здатні продукувати альтеранін, який є токсичним для рослин.
Аналіз мікобіоти насіння соняшника також має важливе значення для агрономії, оскільки соняшник є однією з основних культур в Україні. Виявлення специфічних грибів у насінні соняшника може допомогти виявити можливі ризики для здоров’я рослин і визначити необхідність застосування фунгіцидів або інших агротехнічних заходів. Зокрема, мікобіота насіння соняшника може включати гриби роду Fusarium, які викликають фузаріоз, або патогени роду Verticillium, що впливають на розвиток кореневої системи.
Загалом, аналіз мікобіоти насіння є важливим етапом у прогнозуванні хвороб рослин і розробці стратегій боротьби з грибковими патогенами, що дозволяє забезпечити здоров’я культур, підвищити врожайність та зменшити економічні збитки.
Зв’язатися з нами
